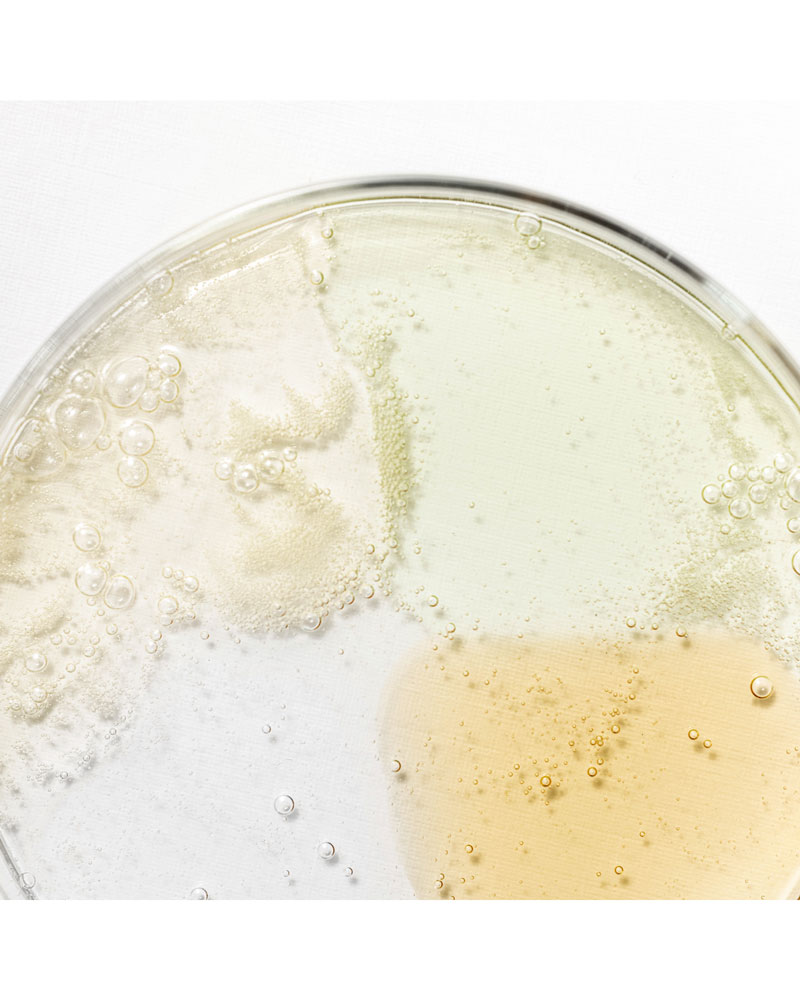

799.00 ₴ Оригінальна ціна: 799.00 ₴.500.00 ₴Поточна ціна: 500.00 ₴.
Набір із 4 сироваток Beauty of Joseon — для пігментації, акне, тьмяності та зволоження. Мініформат для тесту чи подорожі
Є в наявності
Оновіть рутину догляду за шкірою разом із Hanbang Serum Discovery Kit від Beauty of Joseon — набір з чотирьох мініатюр найпопулярніших сироваток, створених за принципами корейської косметології. Це ідеальний формат, щоб випробувати засоби перед покупкою повнорозмірної версії, або взяти у подорож.
У кожній сироватці поєднано потужні рослинні компоненти та сучасні активи, які цілеспрямовано працюють із різними проблемами шкіри — почервонінням, пігментацією, жирністю, запаленнями, втратою пружності тощо.
У наборі:
1. Green Tea Calming Serum (10 мл)
Заспокійлива сироватка для чутливої шкіри з 76% гідролату зеленого чаю, екстрактом центели та 2% пантенолом.
✔ Зменшує запалення
✔ Пом’якшує і зволожує
✔ Відновлює баланс
2. Glow Serum Propolis and Niacinamide (10 мл)
Освітлювальна сироватка з 60% екстракту прополісу, 2% ніацинамідом і 0,5% бетаїн-саліцилатом.
✔ Освітлює пігментацію та постакне
✔ Регулює вироблення себуму
✔ Зменшує почервоніння
3. Glow Deep Serum Rice and Alpha-Arbutin (10 мл)
Сироватка для вирівнювання тону шкіри з 68% гідролату рису та 2% альфа-арбутином.
✔ Усуває пігментацію
✔ Зволожує
✔ Освітлює і пом’якшує
4. Ginseng Revive Serum (10 мл)
Відновлювальна сироватка з 63% гідролату женьшеню, 3% муцину равлика та ніацинамідом.
✔ Підвищує еластичність
✔ Пожвавлює тьмяну шкіру
✔ Стимулює регенерацію
✅ Кому підійде цей набір?
✔ Жирна та комбінована шкіра
✔ Схильна до акне
✔ Чутлива та зневоднена
✔ Шкіра з пігментацією, почервонінням, що потребує оновлення
Спосіб застосування:
На очищену та тонізовану шкіру обличчя нанести 2–3 краплі сироватки, рівномірно розподілити, уникаючи ділянки навколо очей.
Використовувати щодня вранці та/або ввечері, залежно від потреб шкіри.
Можна чергувати сироватки відповідно до стану шкіри або комбінувати їх між собою.
У наборі:
-
4 сироватки по 10 мл
-
Упаковано у фірмову коробку Beauty of Joseon
Де придбати:
Оригінальний набір Hanbang Serum Discovery Kit Beauty of Joseon доступний на greenshop.in.ua. У нас ви знайдете корейську косметику, засоби для догляду за будь-яким типом шкіри, а також новинки першими.
Підписуйтесь на Instagram, щоб дізнаватися про оновлення!
Дивіться відеоогляди на YouTube — протестовано нашими косметологами!

Beauty of Joseon (Б'юті оф Джосан) – марка доглядової косметики, натхненна доглядом у династії Джосан (XIV-XIX ст. у Кореї). Заможні жінки використовували в догляді за собою рослинні інгредієнти, що притаманні східній традиційній медицині.
З тих часів наука значно пішла вперед, тому Beauty of Joseon використовують як традиційні інгредієнти, так і сучасні.
Наприклад, зірковий продукт – сонцезахисний крем – поєднує в собі 30% екстракту рисових висівок, які використовували багато століть для освітлення шкіри, та найсучасніші сонцезахисні фільтри, як от тіносорб М.
Beauty of Joseon це cruelty free бренд, тобто не тестує косметику на тваринах та не продає у країнах, що вимагають таке тестування.
Beauty of Joseon це cruelty free бренд, тобто не тестує косметику на тваринах та не продає у країнах, що вимагають таке тестування.
Сонцезахисний стік Beauty Of Joseon Matte Sun Stick Mugwort+Camelia SPF 50+ PA++++ 18 г
В наявності
580.00 ₴Beauty Of Joseon Matte Sun Stick SPF 50+ PA++++. Матова формула, без жирного блиску, охолоджуючий ефект. Для всіх типів шкіри. greenshop.in.ua
Сонцезахисний крем Beauty of Joseon Relief Sun Aqua-Fresh: Rice + B5 SPF50+ PA++++, 50 мл
В наявності
680.00 ₴Легкий сонцезахисний крем Beauty of Joseon з рисовою водою та пантенолом. SPF50+ PA++++, антиоксидантний догляд, освітлення тону, ідеальний для жирної шкіри.
Доставка
Відправляємо замовлення щодня з понеділка по суботу з Києва.
Стандартний термін відправки — 1–3 робочі дні.
Доставка службами Нова пошта та Укрпошта — зазвичай 1–2 дні, залежно від міста.
Самовивіз не передбачений, але можна отримати замовлення день-у-день у відділенні Нової пошти №203 (Київ).
Після відправки одразу надсилаємо номер накладної (SMS).
Оплата
Онлайн на сайті — швидко та безпечно: plata by mono або LiqPay
(Visa / Mastercard, Apple Pay та Google Pay).Оплата частинами від ПриватБанку — до 6 платежів.
Накладений платіж (Нова пошта): комісія служби доставки — 20 грн + 2%.
Для підтвердження замовлення діє передоплата карткою - 150 грн (страховий платіж).
Важливо знати
Будь ласка, перевіряйте посилку при отриманні. У разі пошкодження одразу оформіть претензію на пошті — усі відправлення застраховані.
Якщо раптом трапився брак — обмінюємо товар за наш рахунок згідно з правилами повернення.
НЕЩОДАВНО ПЕРЕГЛЯНУТІ
СХОЖІ ТОВАРИ
В наявності
В наявності
В наявності
В наявності
В наявності
В наявності
В наявності
В наявності

Автозасмага
Автозасмага Засмага
Засмага Захист від сонця SPF
Захист від сонця SPF
Відгуки
Відгуків немає, поки що.